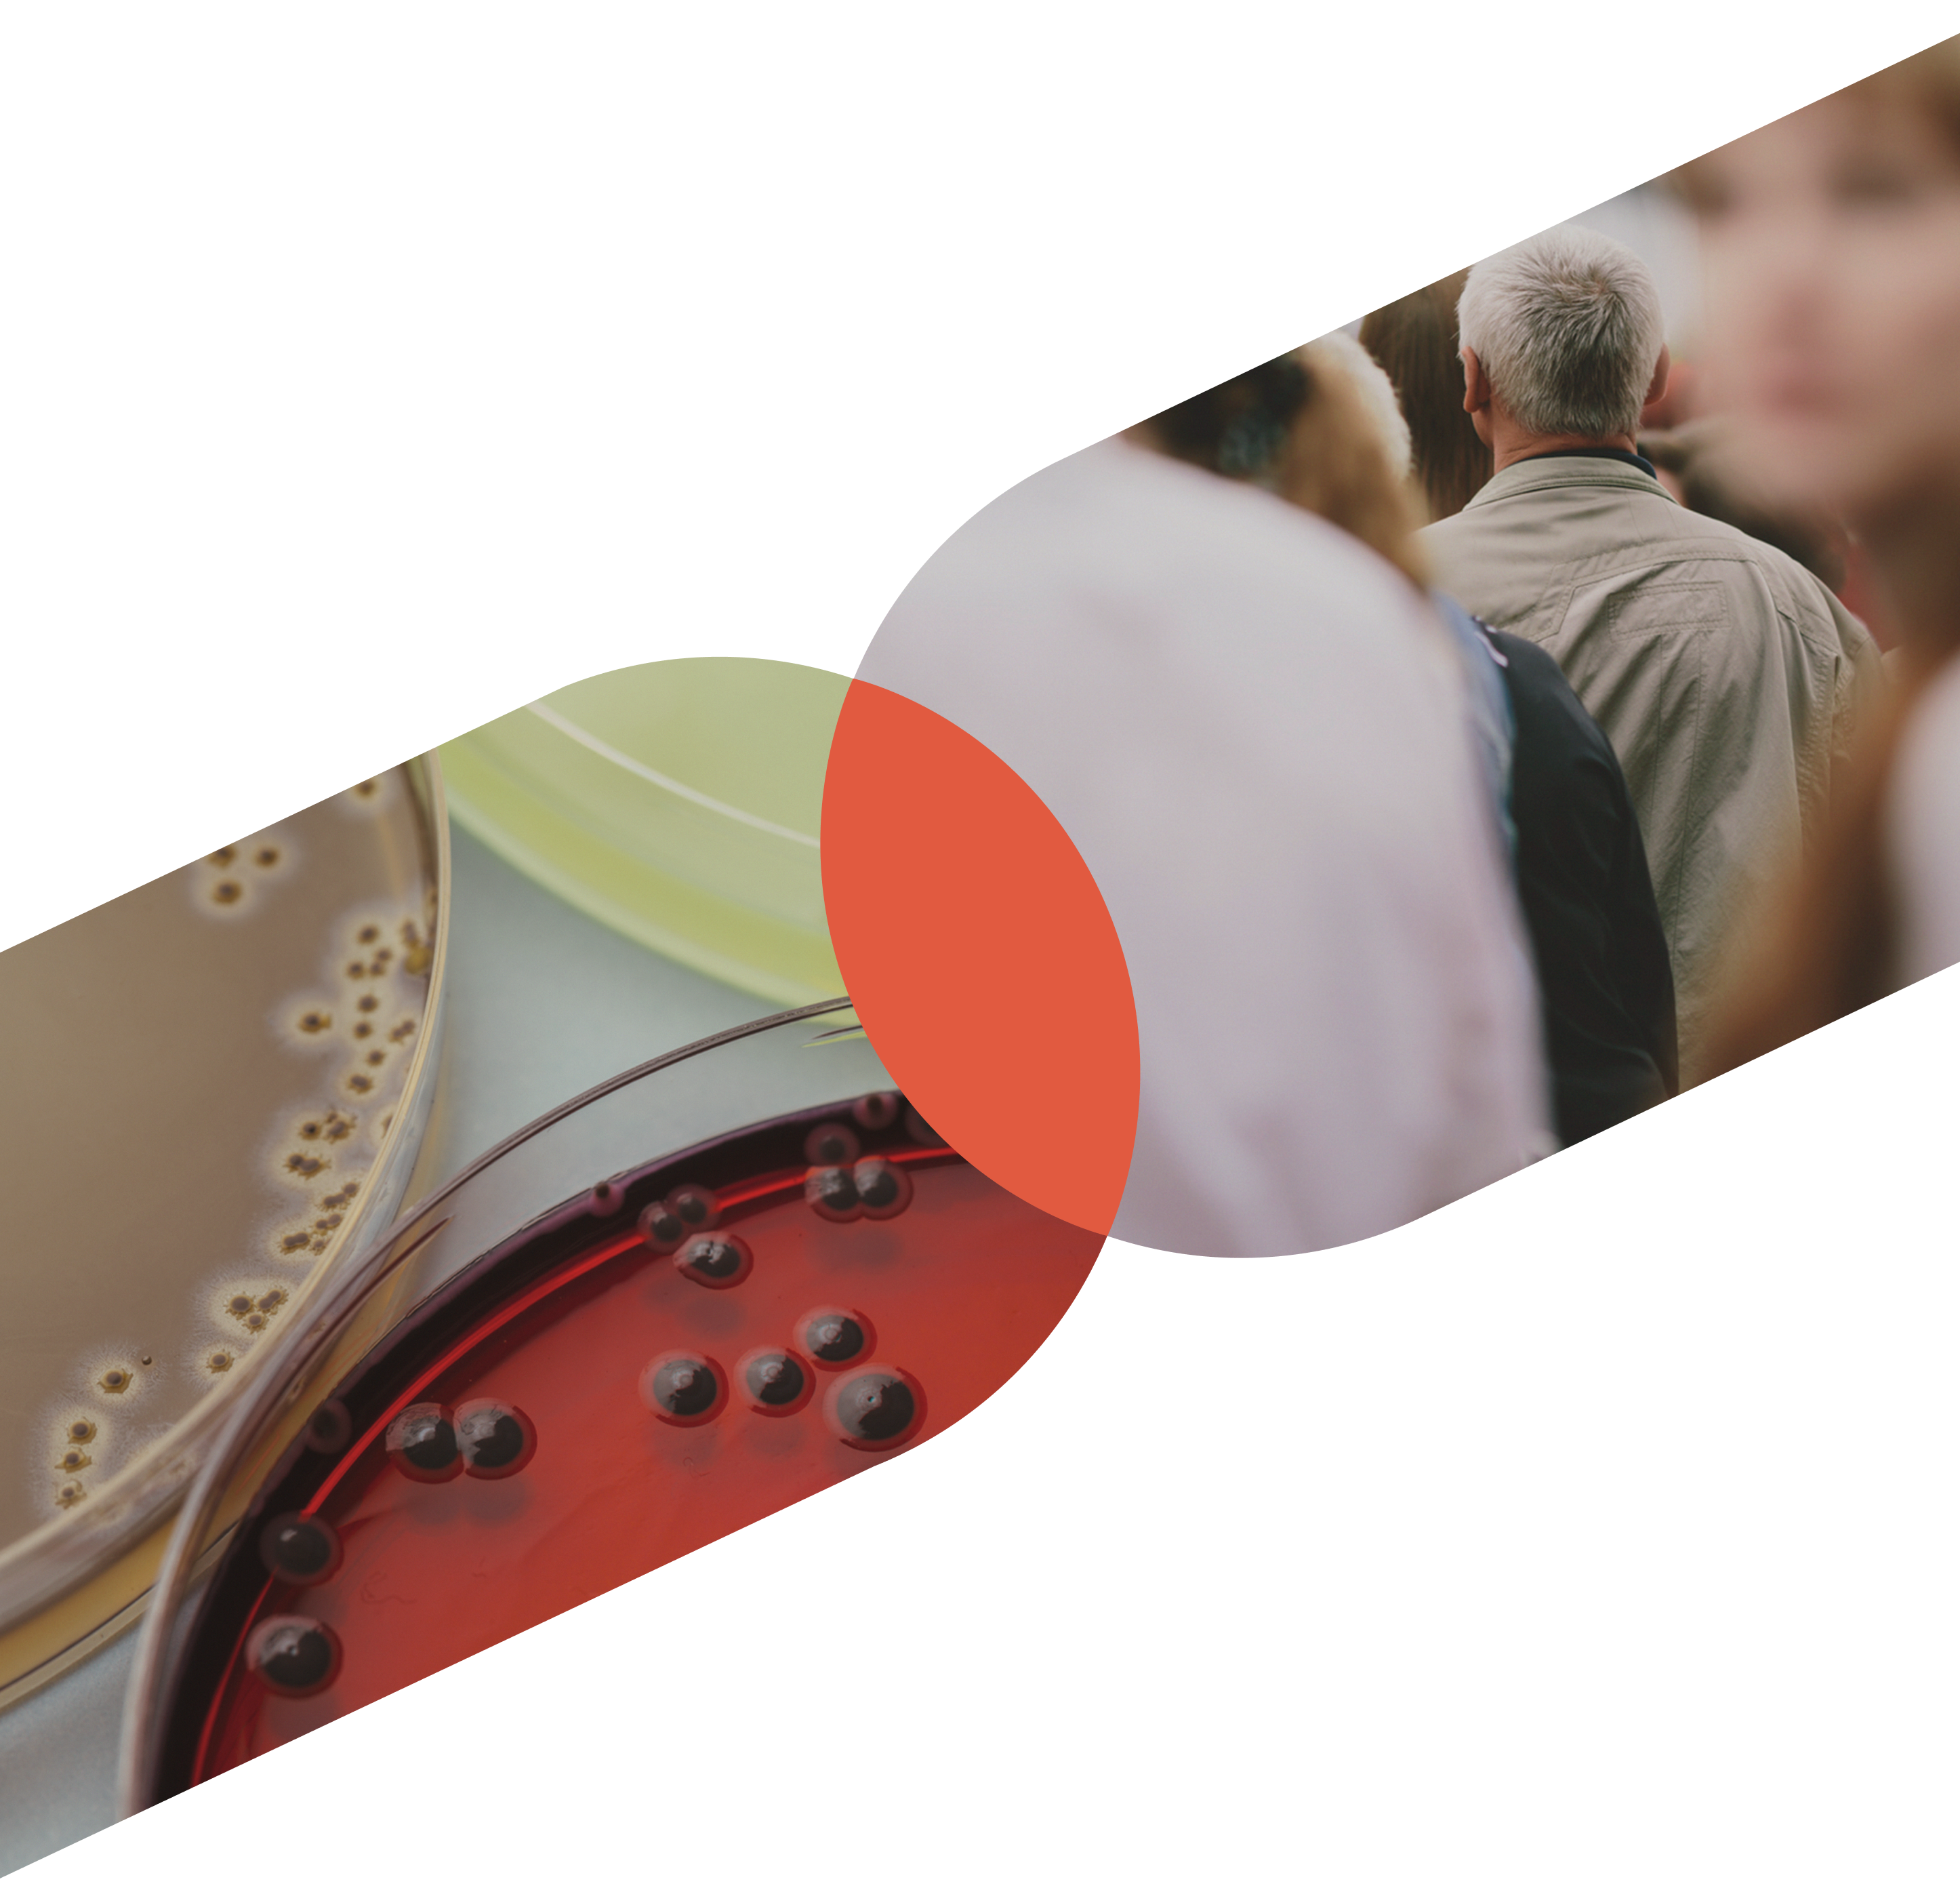
Conectamos<br> la innovación con<br> inversores privados

Llevamos a cabo todo
tipo de proyectos gracias a vías de financiación
pensadas a medida.
Conectamos
la innovación con
inversores privados
Porque apostamos por todos esos proyectos I+D
que nos hacen creer en una sociedad mejor.
Con ganas de hacer el cambio realidad
Somos una empresa del Grupo ABANCA especializada en conectar inversores privados con ideas que compartan las mismas inquietudes
Con ganas de hacer el cambio realidad
Nos enfocamos en proyectos de I+D a los que ayudamos con nuestra experiencia técnica y conocimiento.
Les escuchamos y desarrollamos un plan específico para cada uno, con una respuesta a medida. Y pasamos de una idea a una realidad. Porque creemos en estos proyectos como herramientas de cambio para mejorar las cosas.
Qué ofrecemos
Para ideas innovadoras o inversores privados
¿Una buena idea
con potencial?
¿Quieres invertir en
lo que crees?
Te ayudamos a encontrar ese proyecto de
I+D en España con el que conectar tus esfuerzos
de responsabilidad social.